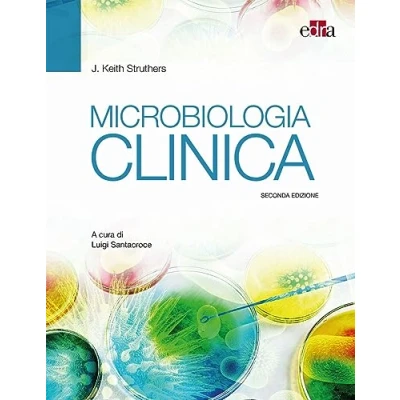

Microbiologia Clinica
Confronta i webshop (1)
Shop


Prezzo


Pagine: 288, Edizione: seconda, Copertina flessibile, Edra

Specifiche del prodotto
Specifiche del prodotto




